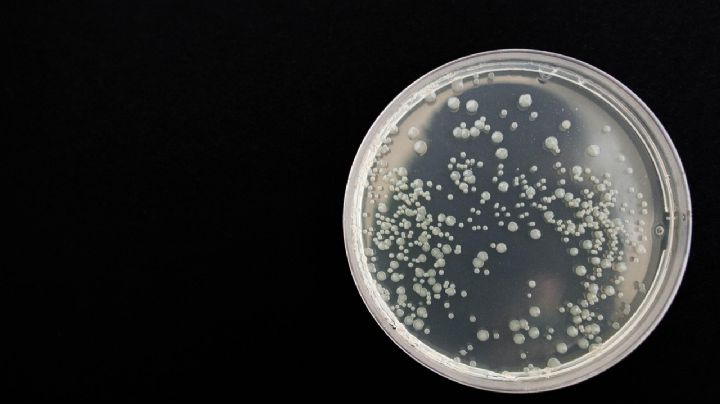
Vetan a empresa por brotes de bacterias

Fiscalía del Edomex obstaculiza reparación por muertes de bebés por klebsiella oxytoca
28/11/2025 | La Fiscalía mexiquense ha frenado los acuerdos de compensación para las 13 familias afectadas, pese a que la empresa responsable ya presentó cheques en audiencia, señala la asesora legal